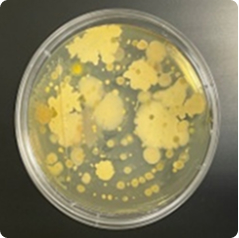

Clean Room
洁净室寄售管理
即将进行的洁净室性能评估,
需要有专业的管理来准备。

随着工业技术高度集成化,直接或间接参与生产的人力资源、环境、设备、原材料、公用设施等
有必要保持最佳条件以满足适当的标准。有必要管理和控制空气中的颗粒物。
为提高生产良率、加强技术竞争力,对洁净室进行自主质量管理,
外部质量保证也得到保证。获得韩国空气清洁协会的集团质量认证。
随着洁净室性能评估实施在即,您的洁净室环境是否得到了妥善管理?
服务流程
- 绩效评估流程
-
步骤 1
收据
- 申请第三方洁净室公司
- 制造产品性能评估请求
- 要求定期进行洁净室评估
第 2 步现场验证
- 洁净室详细位置及简图
- 洁净室设计条件
- 查看产品和评论位置
步骤3绩效评估
- 颗粒物/温湿度/压差
- 根据客户要求添加商品
步骤4签发成绩单
- 验收后编制并出具检测报告
- 环境改善点建议
服务项目
- 洁净室解决方案和
技术能力 -
01
优化洁净室环境
- 室内环境测量及巡检
- 问题相关响应
- 异常情况现场核查
- 通过 3D 气流分析识别根本原因
C/R遍历验证在线监控AMC 控制环境验证02确保核心设备性能
- 设备内部FFU及环境验证(T.A.B)
- 设备运行过程中的实时环境监测
- 离子发生器/精确评估静电水平
微环境晶圆曝光环境验证防止ESD颗粒吸附P/计数器和 S/Com03柔性制造系统
- 建立并维护稳定的FMS系统
- 定期评估测量设备的可靠性
- 发生 FMS 问题时立即采取紧急响应
系统管理实时分析综合环境评估P/计数器和 S/Com04离子发生器和静电管理
- 从 ESDA 角度控制静电污染
- 精确评估和改进离子发生器的性能
- 静电控制与测试
离子发生器性能评估防止ESD颗粒吸附房间/设备环境评估05微污染评估与分析
- 建立并维护稳定的FMS系统
- 定期评估测量设备的可靠性
- 出现 FMS 问题时立即采取紧急响应
系统管理实时分析综合环境评估P/计数器和 S/Com
- 详细的技术服务
-
01
洁净室环境
在线监控
- 实时分析和系统管理
T.A.B
- 综合环境评估
C/R遍历验证
- 环境验证
02设备内部环境
微环境
- 晶圆曝光环境验证
- P/计数器和 S/Com
离子发生器性能评估
- 防止ESD颗粒吸附
- 房间/设备
03实用质量
DIW质量
- 超纯水水质验证
- 18米 DIW 监控
化学金属趋势
- 金属浓度评估
- 去离子水/过氧化氢/氨水
04体外循环CB
工艺审核
- 变更点控制和工人、建筑等
问题
环境评估
- 变更区域环境污染评估
- 技术能力
-
01
3D气流分析和CFD模拟
通过准确识别洁净室内气流停滞或涡流发生的点,防止污染物扩散并保持最佳的空调系统效率。
3D气流分析设备拥有最先进的3D超声波风速计
精确测量现场的气流。
CFD 模拟通过计算流体动力学(CFD)模拟
改变设备布局或新建工程时可能发生
提前预测气流变化并做好准备。02颗粒物和空气污染成分分析
除了测量污染程度之外,我们还精确分析污染物的成分,以追踪污染源并提出根本解决方案。



- 生物良好生产规范
-
洁净度等级 ISO 等级编号 浮游细菌 寄生细菌 表面真菌(设备) 一个 5 < 1 < 1 < 1 B 6 ≤10 ≤5 ≤5 C 7 ≤100 ≤ 50 ≤ 25 D 8 ≤200 ≤100 ≤ 50

- 生物洁净室
微生物学评估 -

重点采样分析项目
- 富裕群体
- 使用收集器
- 寄生细菌
- 忽视评估
- 表面真菌
- 直接捕获
- 孵化器
- 微生物培养
- 微生物
评估 - 视觉确认